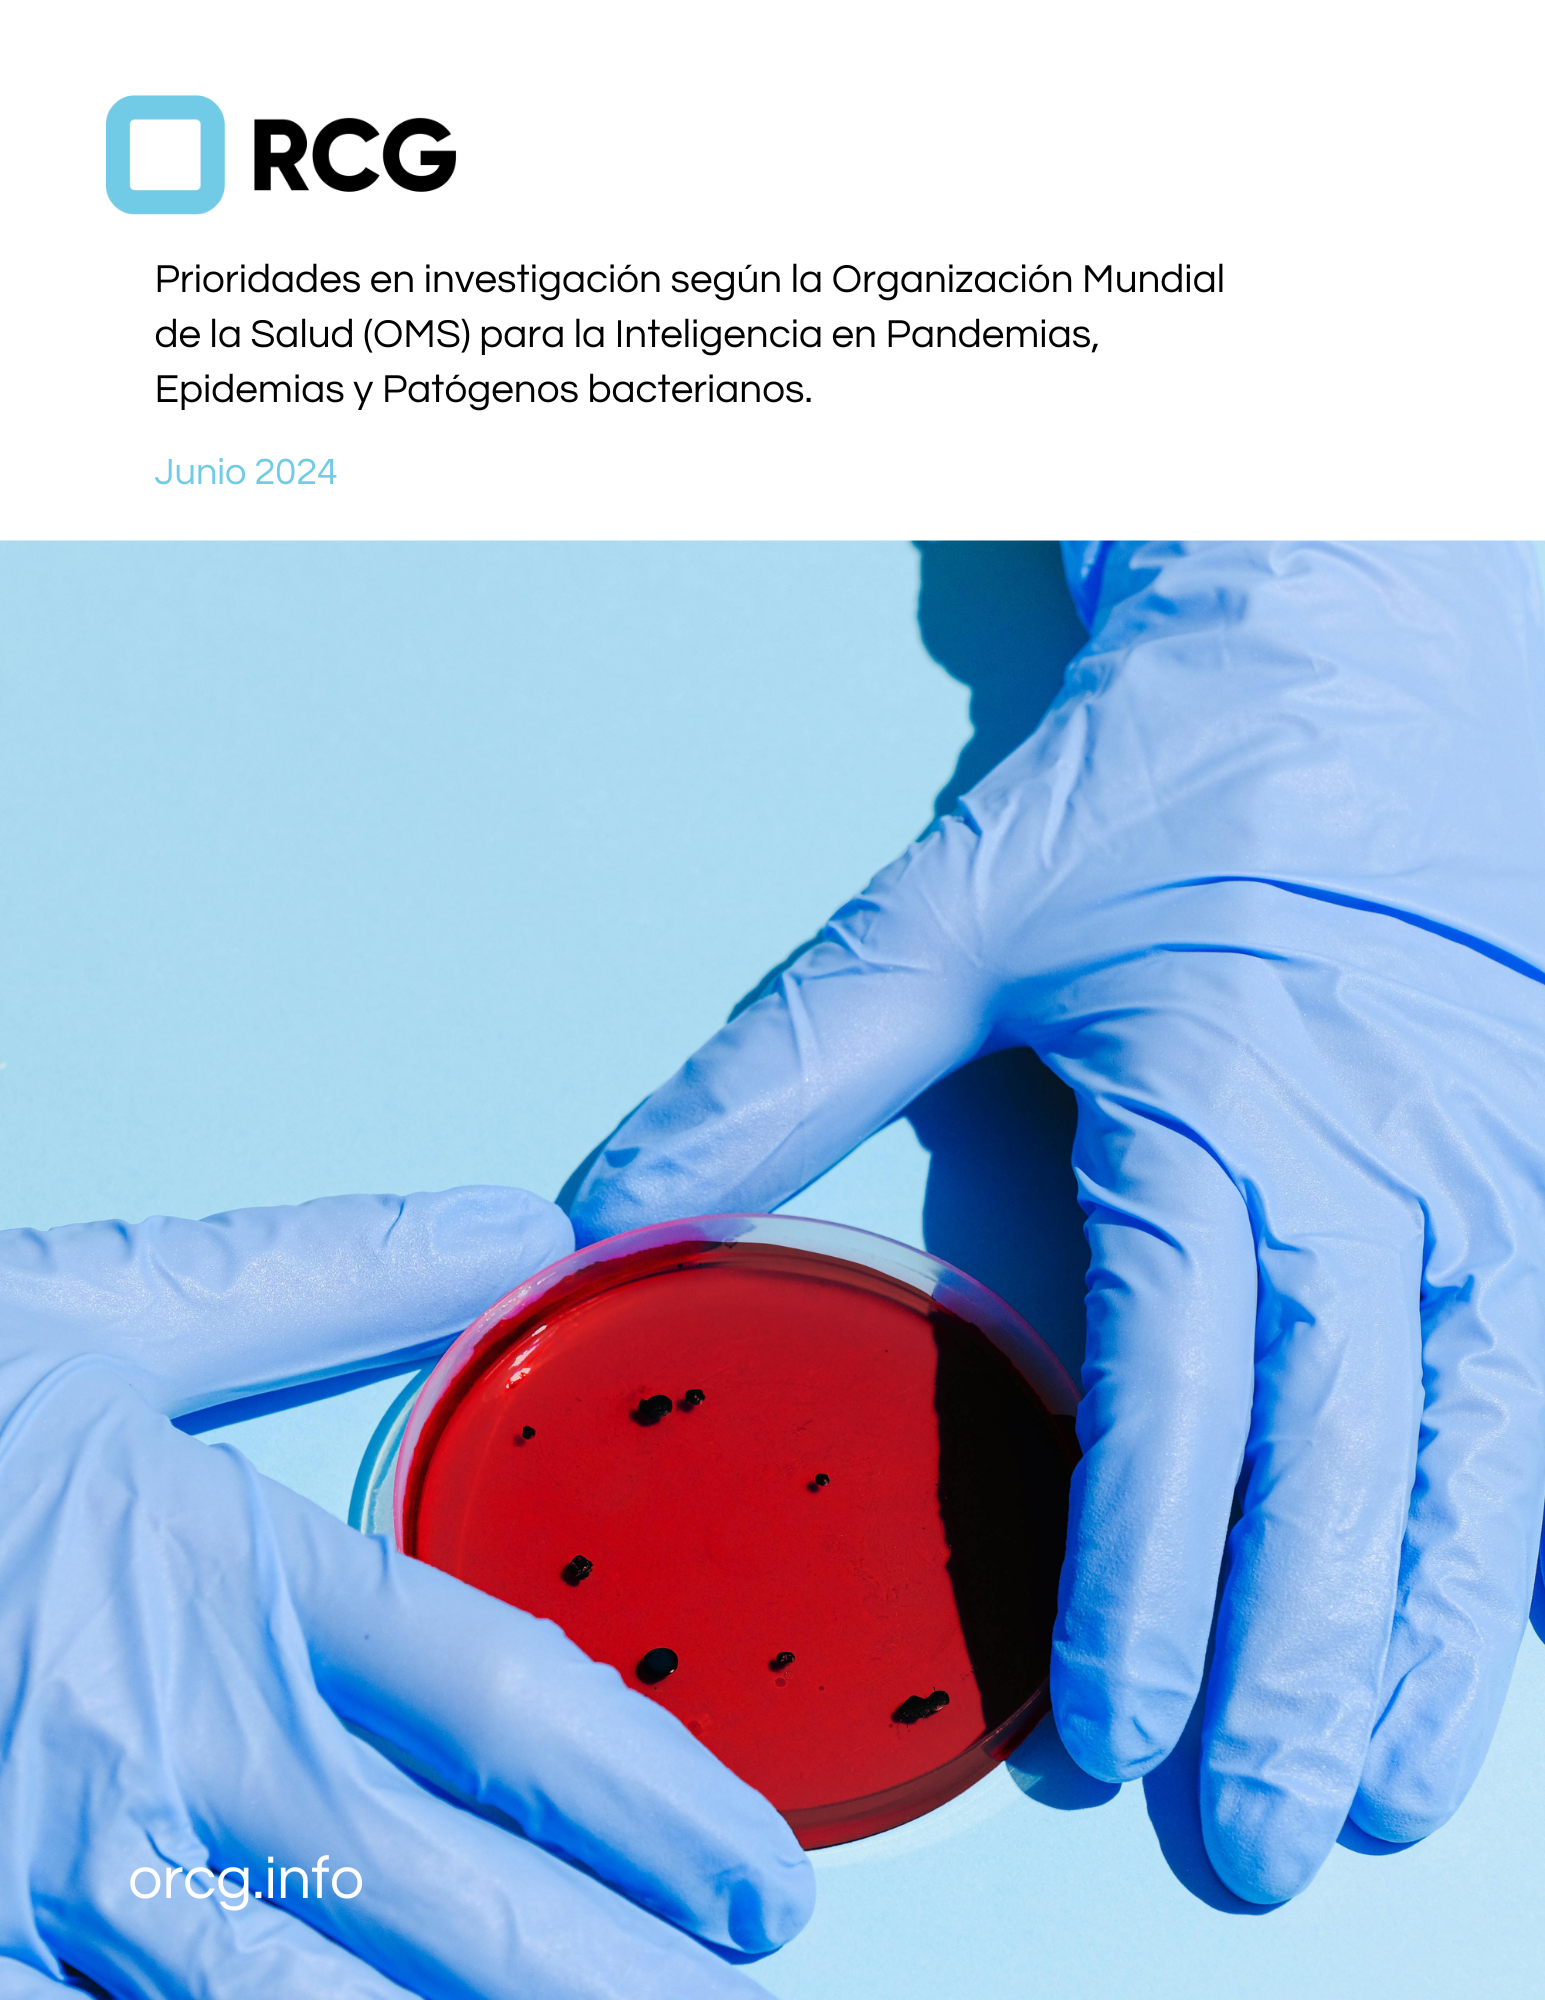

Prioridades en investigación según la Organización Mundial de la Salud (OMS) para la Inteligencia en Pandemias, Epidemias y Patógenos bacterianos.
Por: Michelle Bruno
Resumen
Esta nota pretende sintetizar los informes técnicos realizados por la Organización Mundial de la Salud (OMS) en mayo de este año sobre la priorización de la investigación en inteligencia para pandemias y epidemias, junto con una guía actualizada de patógenos bacterianos prioritarios. Así mismo tiene como fin identificar y compartir las prioridades de investigación epidemiológica y sobre patógenos bacterianos relevantes.
El objetivo es que organizaciones como la nuestra puedan centrar sus esfuerzos de investigación, iniciativas, producción de contenido o fondos de acuerdo con estas prioridades mundiales. Además de ser de utilidad como una guía para los tomadores de decisiones relevantes en la prevención, preparación y respuesta a futuras pandemias o Enfermedades Infecciosas Emergentes (EIE) y Reemergentes (EIR). Para una revisión profunda de estos contenidos, se recomienda consultar los reportes oficiales de la OMS.
Prioridades en Inteligencia para Pandemias y Epidemias
De acuerdo con la información obtenida en el informe técnico de la Organización Mundial de la Salud (OMS, 2024), la investigación en inteligencia para las pandemias y epidemias se ha convertido en una herramienta fundamental para la toma de decisiones en salud pública global. Esta investigación integra información considerando los distintos métodos de vigilancia, incluyendo enfoques tradicionales, basados en eventos, y contextos comunitarios, con el fin de evaluar los riesgos de salud pública de manera más efectiva. Esta integración permite a los tomadores de decisiones adoptar medidas más informadas y precisas para la salud pública.
A partir de la pandemia de COVID-19, la vigilancia epidemiológica ha pasado por una transformación significativa gracias a las innovaciones en ciencias de datos y servicios de laboratorio. Estas mejoras han aumentado nuestra capacidad para detectar, evaluar y responder a nuevas amenazas a la salud pública. Sin embargo, aún se necesitan esfuerzos considerables para convertir estos avances en aplicaciones prácticas para la vigilancia de patógenos.
La Organización Mundial de la Salud (OMS) busca, a través de estos ejercicios, priorizar esfuerzos para reforzar los sistemas de vigilancia epidemiológicos en aplicaciones del mundo real. Esto también establece un marco para la investigación deseada dentro de la comunidad científica, promoviendo la colaboración interdisciplinaria para resolver problemas complejos de salud pública. Este esfuerzo reconoce la naturaleza “multifacética” y global del desafío de salud pública, requiriendo esfuerzos interdisciplinarios y colaboración entre diversos expertos.
Para llevar a cabo este ejercicio de priorización, se crearon grupos de trabajo con expertos que representaran diversas áreas de especialidad, géneros, ubicaciones geográficas y sectores. Este ejercicio se llevó a cabo en seis etapas: Definición del marco sobre el que se trabajaría, Encuesta de expertos sobre brechas existentes en la investigación, Análisis y síntesis de los datos de la encuesta, Formulación de declaraciones de investigación, Validación de las declaraciones, Ejercicio de priorización y finalmente publicación de resultados. Para este ejercicio participaron 160 expertos que inicialmente realizaron 900 “Declaraciones” sobre investigaciones prioritarias que fueron filtradas hasta obtener 23 en órden de importancia. Para mayor información acerca del proceso de priorización revisar el Anexo 1.
A partir de este ejercicio, los expertos a nivel global reconocieron 23 investigaciones prioritarias, clasificadas en tres pilares: Mejora de Datos, Mejora de Decisiones y Mejora de Análisis. La mayoría de las prioridades se centraron en el pilar de "Mejores Decisiones", con 9 investigaciones, mientras que en los pilares de "Mejora de Datos" y "Mejora de Análisis" se seleccionaron 8 y 6 respectivamente (Figura 1).
El pilar de "Mejores Decisiones" se enfoca principalmente en las áreas de "Gobernanza" y "Evidencia para políticas públicas". En cuanto a gobernanza, se propone desarrollar marcos éticos y legales para compartir datos entre sectores, niveles administrativos o disciplinas, preservando la seguridad y evitando riesgos de privacidad. También se menciona la necesidad de comprender diferentes modelos de gobernanza para implementar decisiones a partir de evidencia, especialmente a nivel nacional y subnacional.
Figura 1. Representación de prioridades en inteligencia de pandemias y epidemias. A) muestra el porcentaje de investigaciones prioritarias realizadas por pilar, mientras que los apartados B., C. y D. representan el porcentaje de áreas en las que cada pilar ha enfocado sus investigaciones.
En la sección de “Evidencia para políticas públicas", se destaca la necesidad del desarrollo de mejores estrategias de comunicación de información sobre riesgos en salud pública para los tomadores de decisiones, permitiendo decisiones rápidas y efectivas, por ejemplo mediante la disponibilidad de "dashboards", es fundamental comprender la estructura y el poder de decisión de los "stakeholders" y crear herramientas o métricas para determinar cuándo debe intervenir cada parte en el manejo del riesgo. Dentro de las primeras tres posiciones, la investigación en la posición #3 de este pilar trata sobre el tema "Estándares de Calidad", destacando la necesidad de metodologías eficientes para la retroalimentación rápida después de implementar una intervención en vigilancia y respuesta epidemiológica, con el objetivo de ajustar y mantener siempre intervenciones costo-efectivas.
Aunque la mayoría de las prioridades se centran en "Mejores Decisiones", el primer lugar lo ocupa una investigación del pilar de "Mejora de Datos" en el subtema de "Inteligencia Artificial (IA) y Avances Tecnológicos", que propone el desarrollo de nuevos métodos de diagnóstico (Tabla 1). Esta declaración destaca la necesidad de desarrollar métodos de diagnóstico avanzados mediante el uso de nuevas tecnologías, como la inteligencia artificial, para mejorar la rapidez de los diagnósticos y guiar una respuesta mucho más efectiva.
Como se observa en la Figura 1, en el pilar de "Mejora de Datos" la mayoría de las investigaciones prioritarias se centran en "IA y avances tecnológicos" y "Preparación de datos". Estas investigaciones buscan utilizar la IA para encontrar soluciones innovadoras de diagnóstico, como la detección multi-patogénica, y mejorar la eficacia y precisión de los datos. Además, se enfocan en resaltar la importancia de generar datos con arquitecturas que permitan ser compartidos globalmente durante crisis sanitarias.
Finalmente, en el pilar de "Mejora de Análisis", aunque hay un menor número de investigaciones prioritarias, la mayoría se enfoca en "Marcos Analíticos". Estas investigaciones proponen el desarrollo de nuevos métodos de modelado y pronóstico que permitan comprender y anticipar la re-emergencia o emergencia de patógenos, considerando múltiples “variables complejas”.
Tabla 1. Prioridades de investigación propuestas por expertos en los primeros 3 lugares. Esta tabla muestra las primeras tres posiciones de investigaciones prioritarias propuestas por el grupo de trabajo. Se describe el pilar al que pertenece, el tema y una explicación breve sobre la investigación.
Patógenos Bacterianos Prioritarios
Los patógenos bacterianos resistentes a antibióticos representan un problema de salud pública global, afectando principalmente a países de bajos y medianos ingresos, causando 4.95 millones de muertes tan solo en 2019. Identificar los patógenos bacterianos prioritarios según su resistencia a antibióticos es crucial para orientar la investigación, el desarrollo farmacéutico y las inversiones en función de las necesidades de las crisis de salud pública.
La OMS llevó a cabo un ejercicio de priorización global utilizando el método de análisis de decisiones multicriterio (MCDA, por sus siglas en inglés), evaluando criterios como mortalidad, incidencia, resistencia a antibióticos, transmisibilidad, prevención, entre otros, además de considerar nuevas amenazas recientes identificadas a partir de artículos científicos o reportes. Para la asignación de puntajes por criterio a cada patógeno se empleó la metodología “PAPRIKA” que se basa en encuestas a los expertos del grupo de trabajo, permitiendo determinar el peso y puntaje de cada criterio por bacteria.
La lista de patógenos prioritarios se presenta en la Figura 2, clasificándolos en grupos: “Crítico”, de importancia “Alta” y de importancia “Media”. Los patógenos “Críticos” representan la mayor amenaza para la salud pública debido a las opciones limitadas de tratamiento, alta mortalidad y crecientes tendencias de resistencia a los antibióticos, con pocos o ningún candidato prometedor en desarrollo. Los del grupo “Alto” son patógenos significativamente difíciles de tratar, que causan una enfermedad considerablemente grave, son especialmente difíciles de prevenir, altamente transmisibles y con pocos tratamientos potenciales en desarrollo. Los del grupo “Medio” están asociados con una dificultad moderada para su tratamiento, presenta tendencias moderadas de resistencia, problemas para la prevención o transmisibilidad, y cuenta con relativamente más candidatos para su tratamiento.
En la Figura 2, los patógenos señalados con un recuadro azul son las bacterias nuevas agregadas como prioritarias respecto a la lista de 2017, los marcados con un recuadro rojo son aquellos que han bajado de posición y los señalados con un recuadro verde son los que han subido en comparación con la lista de 2017.
A nivel regional, esta lista es sumamente relevante, ya que algunos de los patógenos listados han mostrado tener una presencia significativa en Latinoamérica. Por ejemplo, Acinetobacter baumannii resistente a carbapenémicos se ha detectado con mayor frecuencia en Centro y Sudamérica, principalmente en Argentina, Brasil, Paraguay, Ecuador, Perú y Venezuela (Ya, et al., 2022; Martins-Gonçalves et al., 2024). Igualmente, las Enterobacterias resistentes a cefalosporina de tercera generación han mostrado una mayor prevalencia en la zona amazónica, especialmente en Brasil (Dos Santos et al., 2024). Además, del grupo “Alto”, más del 60% de los casos de Pseudomonas aeruginosa resistentes a carbapenémicos han sido aislados en el sur y centro de América (Reyes et al., 2023).
A partir de esta priorización, se ha recomendado incrementar los esfuerzos en la implementación de sistemas de vigilancia epidemiológica para obtener mejor información sobre dónde dirigir la investigación y el desarrollo farmacéutico. Con estos patógenos y países de referencia, se espera fortalecer los esfuerzos de colaboración con expertos locales para la implementación de estos nuevos sistemas.
Es importante recordar que esta priorización enfrenta limitaciones de datos, especialmente en regiones con falta de sistemas de vigilancia epidemiológica, lo que podría afectar la evaluación de los patógenos y su incidencia. Por ello, además de realizar priorizaciones constantes y esfuerzos relacionados, es fundamental contar con la estructura de salud pública necesaria para la vigilancia epidemiológica de donde se obtienen estos datos.
Figura 2. Lista de patógenos prioritarios bacterianos, adaptada de OMS (2024). Esta figura enlista los patógenos prioritarios establecidos por el grupo de trabajo de la OMS en 2024. Se muestran respecto a su nivel de prioridad (Crítico, Alto o Medio) y cambios respecto a la lista previa de patógenos bacterianos prioritarios de 2017 (Nuevo, Sube de posición en prioridad o Baja de posición).
Conclusión
El ejercicio de priorización de la investigación epidemiológica y de patógenos es esencial para que quienes participan en la prevención, preparación y respuesta a pandemias, epidemias y crisis sanitarias puedan enfocar sus esfuerzos y recursos según las necesidades globales. La metodología empleada en estos ejercicios es de gran valor, ya que establece un referente para futuras investigaciones alineadas con las necesidades actuales e involucrando de manera representativa a las partes interesadas. Este enfoque puede adaptarse a niveles regionales, nacionales o locales, con el apoyo de expertos, para generar proyectos colaborativos y pertinentes según el contexto específico.
Es crucial considerar continuamente el marco bajo el cual se realiza esta priorización. Si surgen nuevas discusiones entre expertos que identifiquen criterios adicionales o la necesidad de eliminar algunos existentes, debemos estar dispuestos a repetir el ejercicio y analizar posibles cambios en la priorización actual. Es importante que las partes relacionadas a la prevención, preparación y respuesta a epidemias y pandemias siempre mantengan una actitud proactiva y colaborativa, asegurando que las acciones y estrategias estén siempre alineadas con las necesidades emergentes, para así estar mejor preparados para enfrentar futuras crisis sanitarias de manera eficiente.
-
Principales OMS
Research prioritization for pandemic and epidemic intelligence: technical brief. Geneva: World Health Organization; 2024. Licence: CC BY-NC-SA 3.0 IGO.
WHO Bacterial Priority Pathogens List, 2024: bacterial pathogens of public health importance to guide research, development and strategies to prevent and control antimicrobial resistance. Geneva: World Health Organization; 2024. Licence: CC BY-NC-SA 3.0 IGO.
Otras referencias
Dos Santos, L. A., Cayô, R., Valiatti, T. B., Gales, A. C., de Araújo, L. F. B., Rodrigues, F. M., ... & Campanharo, M. (2024). Biodiversity of carbapenem-resistant bacteria in clinical samples from the Southwest Amazon region (Rondônia/Brazil). Scientific Reports, 14(1), 9383.
Martins-Gonçalves, T., Pimenta, J. S., Fontana, H., Esposito, F., Melocco, G., Dantas, K., ... & Lincopan, N. (2024). Acinetobacter baumannii international clone 2 co-producing OXA-23, NDM-1, and ArmA emerging in South America. Antimicrobial Agents and Chemotherapy, 68(5), e00298-24.
Research prioritization for pandemic and epidemic intelligence: technical brief. Geneva: World Health Organization; 2024. Licence: CC BY-NC-SA 3.0 IGO.
Reyes, J., Komarow, L., Chen, L., Ge, L., Hanson, B. M., Cober, E., ... & Satlin, M. (2023). Global epidemiology and clinical outcomes of carbapenem-resistant Pseudomonas aeruginosa and associated carbapenemases (POP): a prospective cohort study. The Lancet Microbe, 4(3), e159-e170
WHO Bacterial Priority Pathogens List, 2024: bacterial pathogens of public health importance to guide research, development and strategies to prevent and control antimicrobial resistance. Geneva: World Health Organization; 2024. Licence: CC BY-NC-SA 3.0 IGO.
Yu, H., Ezpeleta-Lobato, G., Han, X., Carmona-Cartaya, Y., & Quiñones-Pérez, D. (2022). Carbapenamase-producing Acinetobacter baumannii in China, Latin America and the Caribbean: A systematic review and meta-analysis. MEDICC review, 24, 59-69.
-
Ejercicio de priorización de investigación para pandemias y epidemias.
Definición del marco.
Se desarrolló el marco bajo el que se iba a trabajar, la agenda, objetivos y alcance de este ejercicio de priorización considerando siempre la misión de reforzar la inteligencia epidémica y pandémica.
En esta etapa fue que se definieron los pilares y temas en las que sería dividida cada investigación.
Pilares:
Mejora de Datos.
Mejora de Análisis.
Mejora de Decisiones.
Encuesta a expertos sobre brechas existentes en la investigación.
Se trabajó con un grupo de 160 expertos en inteligencia de pandemias y epidemias, asegurando siempre la representación en expertise, áreas de especialidad, géneros, ubicaciones geográficas y sectores de trabajo.
Se llevó a cabo una encuesta en el que se obtuvo la participación de sólo 83 expertos.
Análisis y síntesis de los datos de la encuesta y formulación de declaraciones de investigación.
A partir de la participación de los 83 expertos en la encuesta, se generaron alrededor de 900 “declaraciones” de problemas que atender para la mejora en inteligencia de pandemias y epidemias.
De estas 900 declaraciones se hicieron análisis cualitativos y revisión interna por la OMS para consolidar finalmente 70 “declaraciones”.
Validación de las declaraciones de investigación.
Las 70 “declaraciones” finales obtenidas en la etapa 3 fueron nuevamente discutidas por el grupo de trabajo, generando un total final de 25 “declaraciones” sobre investigaciones prioritarias.
Ejercicio de priorización.
*El grupo de trabajo definió 5 criterios de priorización:
La investigación cubre una brecha clave de conocimiento*Puede tener impacto e informar intervenciones efectivas
*Es factible de implementar
*Sus resultados pueden traducirse en políticas públicas.
*Puede conducir a intervenciones que aumenten la equidad.
En este punto, los 160 expertos iniciales participaron nuevamente en el ejercicio de priorizar cada “declaración” según los 5 criterios establecidos.
Publicación de resultados.
Finalmente, con el análisis de resultados de esta encuesta se obtuvieron las 23 prioridades de investigación que fueron publicadas en el informe de la OMS en Mayo del 2024.